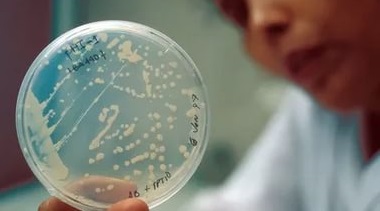
Бактериальный посев

Характерная симптоматика

Молочница у новорожденных легко поддается лечению только на ранних стадиях развития. В запущенных случаях на лечение болезни уходит много времени. При этом возникает необходимость в использовании системных препаратов.
У грудничков кандидоз ротовой полости проявляется следующим образом:
- Появление бляшек на слизистой оболочке.
- Воспаление и отечность вокруг области поражения.
- Чрезмерное беспокойство и капризность.
- Пониженный аппетит и отказ от приема пищи.
Со временем белый налет превращается в плотную пленку, которая покрывает большую часть слизистой и имеет желтовато-коричневый цвет. При попытках удаления данного налета на слизистой оболочке появляются язвочки. При этом существуют большие риски развития таких серьезных осложнений, как инфицирование внутренних органов ребенка или же присоединение вторичной бактериальной инфекции.
В организме взрослого человека имеются полезные микроорганизмы, которые сдерживают рост дрожжеподобной микрофлоры, препятствуя прогрессированию молочницы. У маленьких детей иммунная система еще не в состоянии подавлять активность условно-патогенных организмов, и их численность возрастает. При этом происходит поражение слизистых оболочек, внутренних органов и кожного покрова.
Врачи отмечают, что молочница на языке у новорожденного — распространенное явление, вызванное грибком Candida. При появлении белого налета на языке и слизистой рта родителям следует обратиться к педиатру для подтверждения диагноза. Специалисты рекомендуют не заниматься самолечением, так как это может усугубить ситуацию. Врач может назначить противогрибковые препараты, которые безопасны для младенцев. Также важно соблюдать гигиену: регулярно стерилизовать соски и бутылочки, а также обрабатывать ротик малыша специальными растворами. В большинстве случаев молочница легко поддается лечению, но игнорировать симптомы не стоит, чтобы избежать осложнений.

Классификация кандидоза
У грудничка молочница может протекать в несколько стадий. Каждая из них отличается выраженностью симптоматики. По мере прогрессирования заболевания оно всё сложнее поддается лечению.
Стадии кандидоза у грудных детей:
- Легкая. На слизистой оболочке ротовой полости и на языке присутствуют красные пятнышки. Со временем на них нарастает творожистый налет. Дискомфорт практически отсутствует. Ребенок не отказывается от еды и хорошо спит.
- Средняя. Белый налет более выражен. Если его снять, то можно увидеть кровоточащие язвы, которые доставляют дискомфорт. Ребенок отказывается от еды и перестает сосать пустышку. Появляется беспокойство не только в ночные часы, но и днем.
- Тяжелая. Дрожжеподобная микрофлора поражает не только небо и язык, но также десны и губы с внутренней стороны. У ребенка отмечаются признаки интоксикации в виде повышения температуры тела и слабости. Происходит нарушение кишечной микрофлоры. Лечение в данном случае требует принятия кардинальных мер.
Причины развития
Инфицирование молочницей чаще всего происходит внутриутробно или во время родов, при прохождении по родовым путям в том случае, если женщина заражена. Именно поэтому профилактике кандидоза у беременных женщин уделяют огромное значение. Заразиться грудной ребенок может при контакте со взрослыми людьми, например, при поцелуе. Не исключена вероятность и бытового пути передачи грибка. Маленькие дети постоянно тянут в рот различные предметы, что и может стать причиной заражения. Именно поэтому среди основных причин инфицирования и выделяют недостаточное соблюдение личной гигиены.
Дрожжеподобная микрофлора достаточно быстро развивается при наличии в организме глюкозы. Обратите внимание, что если давать ребенку подслащенную воду или молочную смесь, добавляя в нее сахар, то вероятность развития кандидоза ротовой полости возрастает многократно.
Не следует исключать и такой провоцирующий фактор, как антибактериальная терапия. Неважно, кто проходит курс лечения – кормящая женщина или новорожденный ребенок, находящийся на грудном вскармливании. Антибиотики нарушают микрофлору организма, что чревато прогрессированием дрожжеподобной микрофлоры.
Среди основных причин развития молочницы на языке у ребенка следует выделить следующие:
- Перенесенное хирургическое вмешательство.
- Расстройство функционирования системы пищеварения.
- Гиповитаминоз, рахит и анемия.
- Нарушение процессов метаболизма и сахарный диабет.
Наличие молочницы на языке у грудного ребенка до 6-месячного возраста считается нормой. Главное предотвратить её дальнейшее развитие. Для того чтобы остановить прогрессирование патологического процесса рекомендуется соблюдать личную гигиену и меры профилактики. Обратите внимание, что под видом кандидоза могут развиваться более серьезные заболевания. Именно поэтому ни в коем случае нельзя заниматься самолечением. Только специалист может поставить верный диагноз и назначить эффективную медикаментозную терапию.
Молочница на языке у новорожденного — это распространенная проблема, с которой сталкиваются многие родители. В первую очередь, важно не паниковать. Многие мамы отмечают, что заметили белый налет на языке или щеках малыша, что вызвало у них беспокойство. В таких случаях рекомендуется обратиться к педиатру, который сможет подтвердить диагноз и назначить лечение.
Некоторые родители делятся опытом использования специальных антисептических растворов или противогрибковых препаратов, которые помогают справиться с этой проблемой. Также важно следить за гигиеной полости рта ребенка и регулярно стерилизовать соски и бутылочки. Многие отмечают, что правильное питание мамы и укрепление иммунной системы малыша играют значительную роль в профилактике молочницы. Главное — не заниматься самолечением и доверять профессионалам.

Диагностические мероприятия
Как убрать молочницу с языка у новорожденного ребенка? Для начала нужно выяснить причину развития кандидоза и установить стадию заболевания. Для этого нужно провести доскональное обследование. В первую очередь педиатр или стоматолог проводят визуальный осмотр. Далее ребенку назначаются следующие анализы:
- Соскоб налета с языка. Данный вид лабораторного исследования позволяет выявить разновидность грибка.
- Бактериальный посев. Лабораторное исследование позволяет определить количество условно-патогенных микроорганизмов и назначить максимально эффективные медикаментозные препараты.
- Серологическая диагностика. Дает возможность выявить антитела в организме ребенка для определения степени поражения.
Только после проведения полного обследования может быть определено эффективное лечение. После окончания терапии врач назначает контрольную диагностику. Это необходимо для исключения развития рецидивов.
Лечебные мероприятия
Прежде чем лечить молочницу, следует внимательно ознакомиться с дополнительными рекомендациями. Если не учесть данные моменты, то медикаментозная терапия может не дать должного результата.
Основные правила успешного лечения кандидоза:
- Проводить очищающие процедуры, промывая ротовую полость от налета.
- Исключить из рациона матери продукты питания, в состав которых входит сахар или дрожи.
- Стерилизовать посуду, бутылочки, пустышки и игрушки.
Медикаментозная терапия
Для борьбы с молочницей новорожденному назначают лекарственные средства, в состав которых входит небольшое количество химических элементов, обладающих антимикотической активностью. Как правило, назначаются противогрибковые препараты, предназначенные для местного использования. Системные средства используются только при запущенных формах заболевания.

Можно наносить на пораженные участки мазь «Нистатин» этот препарат обладает выраженной противогрибковой активностью и практически не вызывает побочных реакций. Курс терапии составляет от 5 до 7 дней, что зависит от степени поражения.
В запущенных случаях назначаются системные препараты, например «Дифлазон» или «Дифлюкан». Дозировку должен рассчитывать врач индивидуально, исходя от массы и возраста ребенка. Препараты следует давать детям в жидком виде при помощи чайной ложечки или шприца.
Убирая налет с языка, нужно выполнять процедуру очень осторожно, чтобы не повредить целостность слизистой оболочки. Лечение следует проводить только после консультации с врачом. Необходимы также периодические осмотры во время лечения. Амбулаторный контроль позволяет исключить вероятность недостаточной эффективности используемого препарата и при необходимости назначить другое лекарство. Также врачебное наблюдение позволяет вовремя распознать побочные реакции и уменьшить дозировку либо заменить препарат.
Новорожденным не лечат кандидоз с помощью антибиотиков. Препараты, обладающие антибактериальной активностью, только усугубляют ситуацию.
Лечим нетрадиционными способами
Для того чтобы вылечить кандидоз на языке, следует воздействовать на проблему комплексно. Для этого широко используются средства народной терапии. Они могут быть использованы только для повышения эффективности медикаментозного лечения, но ни в коем случае не в качестве основных мер.
Для того чтобы вылечить молочницу быстрее, можно применять следующие рецепты:
- Пищевая сода. На 200 мл кипяченой воды, охлажденной до комнатной температуры, взять 2 ч. л. пищевой соды. Данное средство помогает остановить прогрессирование дрожжеподобной микрофлоры и предотвратить развитие осложнений. В день следует обрабатывать пораженную грибком поверхность 2-4 раза.
- Зеленка. Появившиеся под налетом язвочки можно смазывать обычной зеленкой. Это помогает им быстрее подсохнуть и зажить. Помните, что нанесение зеленки на поврежденные участки слизистой оболочки доставляет выраженный дискомфорт.
С использованием дополнительных мер вылечить кандидоз удается гораздо быстрее. Перед использованием любого медикаментозного препарата или же средства народной медицины в обязательном порядке нужно консультироваться с врачом. Это позволит исключить вероятность развития осложнений и аллергических реакций.
Молочницы на языке у новорожденных – распространенное и неприятное заболевание, с которым сталкиваются многие мамы. Для лечения кандидоза рекомендуется в данном случае использовать щадящие препараты, предварительно проконсультировавшись с врачом. Не следует заниматься самолечением, так как это может стать причиной развития серьезных осложнений.

Вопрос-ответ
Нужно ли чистить язык от молочницы у младенца?
Молочницу невозможно вытереть. Оральный кандидоз — это грибковая инфекция, развивающаяся в полости рта. Он вызывается оральным кандидозом и оставляет белые пятна на языке, дёснах, внутренней поверхности щёк и нёбе. Для предотвращения распространения инфекции необходимо лечение противогрибковыми препаратами.
Как отличить молочницу от налета на языке у новорожденного?
Нередко это может быть симптомом проявления молочницы у детей. Определить и распознать заболевание просто: если налет покрывает не только язык, а также внутреннюю часть щек и десен, а при его устранении виднеется воспаленная слизистая, то это молочница.
Советы
СОВЕТ №1
Обратитесь к педиатру. Если вы заметили белый налет на языке вашего новорожденного, важно как можно скорее проконсультироваться с врачом. Специалист сможет точно определить, является ли это молочницей или другим заболеванием, и назначить соответствующее лечение.
СОВЕТ №2
Соблюдайте гигиену. Регулярно очищайте ротик малыша с помощью стерильной марли или ватного тампона, смоченного в кипяченой воде. Это поможет удалить налет и предотвратить его распространение.
СОВЕТ №3
Следите за питанием. Если вы кормите грудью, убедитесь, что ваша грудь и соски также чистые. При необходимости используйте специальные антисептические средства, чтобы избежать повторного заражения.
СОВЕТ №4
Не забывайте о профилактике. Если у вашего малыша была молочница, старайтесь избегать контакта с предметами, которые могут быть источником инфекции, такими как игрушки или соски, которые не были должным образом обработаны.